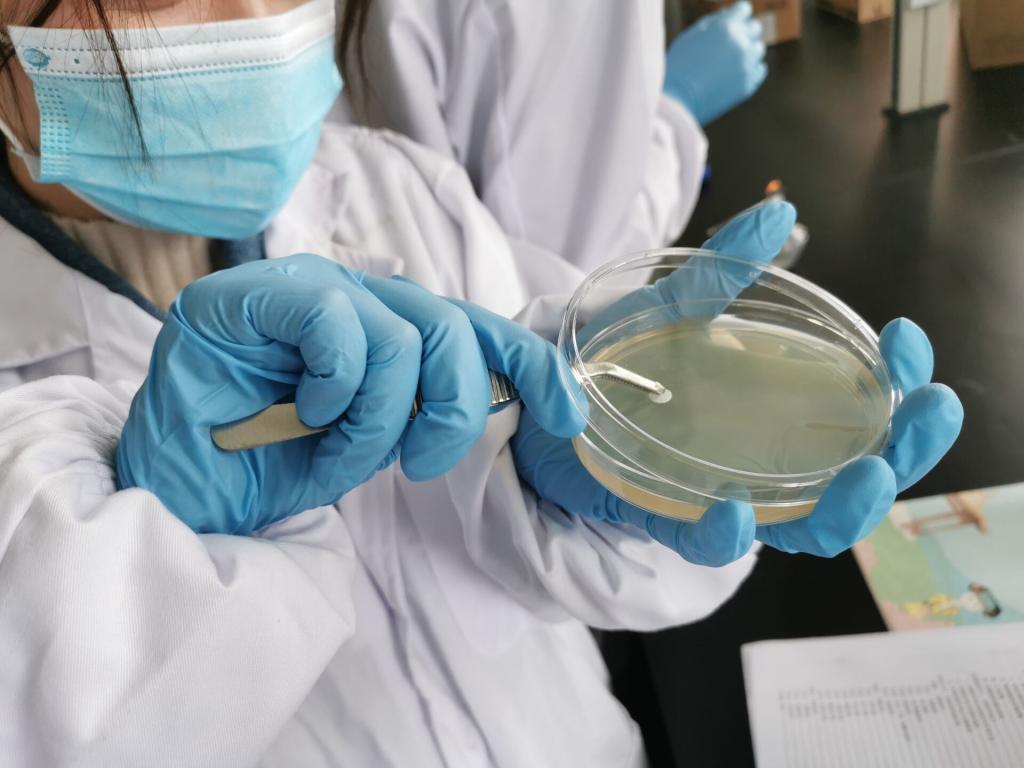

【动物防疫与检疫】
◎培养目标:本专业培养具备动物疫病防疫、检疫基础理论和基本技能,能够从事动物疫病防疫与检疫、食品安全检测等方面的技术和创业型人才。
◎主要课程:动物解剖生理、动物病理、动物微生物及免疫、动物传染病学、动物药理学、兽医公共卫生学与兽医法规、动物寄生虫病防治技术、兽医临床诊断技术、动物防疫技术、动物检疫技术、畜产品加工及卫生检验、兽医生物制品、禽生产、猪生产、牛羊生产、宠物饲养与美容、宠物疾病防治、水产动物疾病防治技术等。
◎职业去向:本专业学生毕业后,可到动物防疫、检疫部门,从事检验检疫、行政执法和管理等工作,也可在各类养殖企业从事生产技术及管理工作。